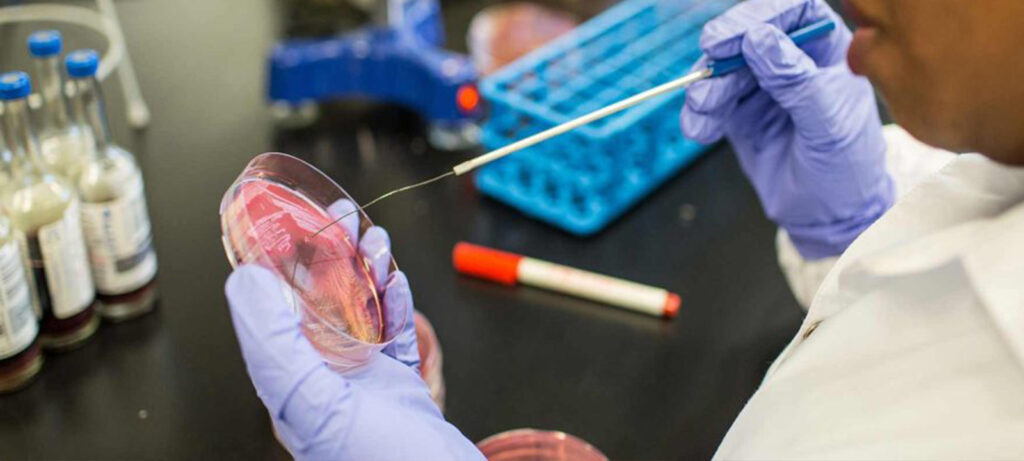

O encerramento da USAID e o corte de financiamento ao Sector Da Saúde reduziram a capacidade nacional de Testagem de tuberculose. O diagnóstico reduziu em cerca de 6% de 2024 para 2025, ano do corte do financiamento externo.
É uma das principais causas de morte entre as doenças infecciosas em todo o país. Anualmente, são diagnosticados pouco mais de 100 mil novos casos de tuberculose, um número que reduziu significativamente após o corte de financiamento ao sector da saúde pelo regime norte americano de Donald Trump.
“Quando nós tivemos o corte de financiamento do Governo Americano, afectou o programa da tuberculose, considerando que nós temos alguns actores comunitários, que prestam serviços para a tuberculose e são financiados por este financiamento externo. Então, isso afectou muito e levou a uma redução de números de casos que eram diagnosticados. Em 2023, nós estávamos em cerca de 116 mil casos de tuberculose diagnosticados e tivemos uma redução de cerca de 9%”, avançou Benedita José, Directora do Programa de Controle da Tuberculose.
Embora os casos de tuberculose em menores continuem uma preocupação, as formas mais graves segundo o ministério da saúde registam-se em adultos.
“As crianças têm a vantagem de poder receber uma vacina contra o BCG, uma vacina que, geralmente, deixa marcas no ombro. Então, esta vacina previne a ocorrência de formas graves, o que significa que temos tuberculose em crianças, mas as formas graves são pouco frequentes (…) Mas nós começamos a ter uma reativação das infecções na fase adulta, o que significa que não devemos nos concentrar nas crianças, mas é preciso haver acções que olhem para a fase adulta”, explicou Benedita José.
O governo pretende eliminar a Tuberculose até 2030, para o efeito, segundo o ministro da saúde que falou na palestra alusiva ao Dia Mundial da Tuberculose, é necessário inovar, pesquisar e melhorar a coordenação.
Historicamente, as províncias de Gaza e Inhambane registam maior número de casos de tuberculose, no entanto, a estatística de 2025 pesou nas províncias de Zambézia e Nampula.